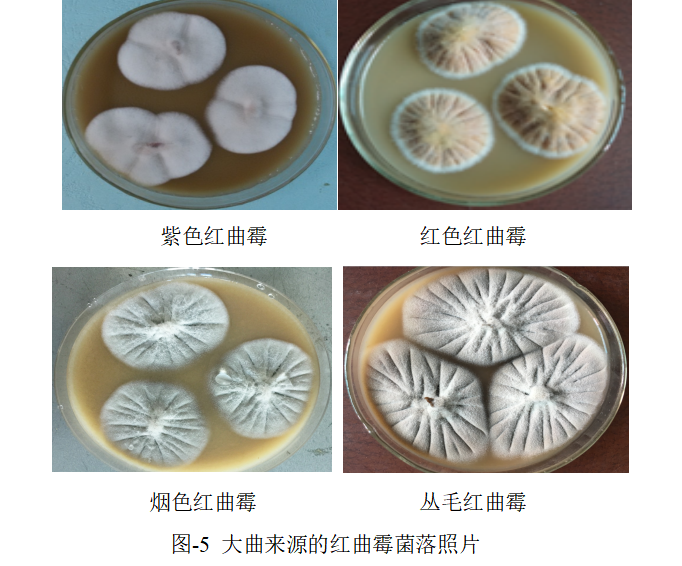
9.png
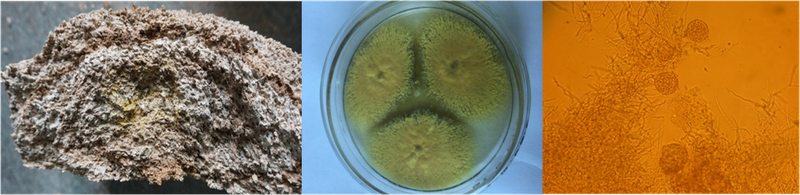
图片1.png

中国白酒技术创新战略发展委员会第四期科研项目报告(2021年-2023年度)
课题名称:大曲微生态演替规律及形成机制研究
完成单位:中国科学院成都生物研究所
❶
立项背景
白酒是中国特色的传统发酵饮品,多菌自然发酵的制酒工艺和蒸馏技术有着独特的技艺和高超的水平。白酒中除了水之外的成分中包括约98%的乙醇和约2%的微量呈香呈味物质,其中2%微量成份的种类和数量决定了白酒的风味和品质。白酒酿造中,微量成份来源于微生物消耗原料所产生的代谢产物,微生物产生的蛋白水解酶、淀粉水解酶、酯化酶、脱酸酶、脱氨酶等复杂酶系,对原料中的淀粉、多糖、单糖、蛋白质、氨基酸、核酸等基质,接力或平行进行降解、合成、转化等各种复杂的生物、化学反应,使原料发生复杂的变化,形成醇、醛、酸、酯、酮等微量成份,不同的微生物产生不同种类和数量的酶,从而形成不同的微量成份。因此,微生物的种类和数量对白酒的风味与品质具有重要的影响。
大曲是白酒酿造微生物的主要来源,以曲药为微生物载体的多菌种混合发酵生产工艺是中国白酒区别于世界其它蒸馏酒的主要特征之一。大曲微生物对糖化、发酵和香味物质的产生发挥着重要作用,是白酒生产不可缺少的关键部分,“曲乃酒之骨”足以说明酒曲在中国白酒生产中起到了十分重要的作用。
大曲是由其中的微生物及其微环境组成的一个微生态系统,微生物种类和数量的演替对这个系统的形成有着重要的作用。大曲制作以小麦为主要原料,发酵初期,大曲中的微生物数量极少,主要以孢子,单个菌体的形式存在,随着发酵的进行,不同微生物由于生长繁殖速度不同,而导致数量存在差异,调节温度、酸度、水分等大曲微环境发生变化,随着大曲微环境的变化,某些微生物菌株逐步停止生长,甚至死亡,其它的一些菌株开始生长繁殖,最后实现水分、酸度、酶活性和微生物群落的空间平衡,从而形成稳定的大曲微生态系统。
早期大曲微生物演替规律研究主要采用平皿计数法,通过将大曲样品适当稀释后在一定的培养基上培养,形成单菌落后计数。这种方法测定活菌数,可以消除掉已经死亡的菌株干扰,但缺点是只能计数细菌、霉菌、酵母、乳酸菌等微生物的数量,仅能比较概略地了解几大微生物类群大概的变化趋势,不能确定真正参与大曲发酵过程的功能微生物的种属。近年分子生物学技术的发展尤其高通量测序成本的降低为大曲微生物的演替研究提供了新的技术手段,促进了对大曲制作过程微生物演替规律的认识,然而该方法同样存在明显的缺点,由于受大曲中微生物分布不均一、从大曲复杂成分中提取总DNA提取效率低、测序结果数据处理方法等因素的影响,导致高通量测序的结果重复性差。同时,高通量测序也只能反应大曲微生物群落组成情况,无法反应群落动态演替过程以及微生物之间的相互关系,并且无法消除死亡微生物的影响,不能如实的反映大曲制作过程微生物种类和数量的变化,不能真正确定具体微生物菌种在大曲制作过程中的演替规律。然而,准确定量地分析大曲中主要微生物的生长繁殖过程,阐明大曲微生态系统的演替规律及形成机制,阐明大曲培养功能微生物,有利于大曲生产过程工艺参数优化,促进大曲机械化、智能化生产。
本项目拟选择优质中高温大曲为研究对象,开展以下研究内容:
(一)采用三代测序技术分析中高温大曲制作关键工序微生物种分类水平上的种类。以此为指导,设计针对性的分离培养策略,针对性分离中高温大曲中的优势功能微生物并研究其在种水平上的分类学地位,建立中高温大曲微生物菌种资源库。
(二)针对不同微生物特有基因序列,设计专一引物,结合qPCR技术对大曲制作关键工序中不同微生物菌种的菌数进行定量分析,确定不同微生物菌种在大曲发酵过程中的生长、繁殖及消亡过程,全面分析微生物在大曲微生态形成过程中的演替规律,确定不同微生物菌种在大曲制作过程中的角色--功能菌(参与大曲发酵)和非功能菌(仅存在但不参与大曲发酵),进而确定中高温大曲的关键功能微生物。
(三)利用共培养技术手段剖析不同功能菌种之间的生物学互作关系,利用硅胶柱层析、高效液相色谱(HPLC)、高效液相色谱质谱联用(HPLC-MS)等色谱分离技术和核磁共振(NMR)、高分辨质谱(HRMS)、红外(IR)、紫外(UV)色谱波谱等现代分析化学技术手段,研究阐明优势菌化学生态学作用的物质基础;(四)分析功能菌代谢产物在大曲培养过程中的生成、累积和分解过程,阐明功能菌在微生态系统演替过程中的化学生态学作用机制。
目前,我们主要对中高温大曲的微生物群落组成进行了分析,分离纯化了部分关键菌株,并对部分菌株的代谢产物进行了初步分析。
❷
主要研究内容
2.1 中高温大曲微生物菌种资源库的建立
采用三代测序技术分析中高温大曲制作关键工序的细菌和真菌群落结构,以测序结果为指导,针对菌种的生物学特性,设计特定的菌种分离培养策略,建立关键菌株可培养分离技术、特色菌株筛选模型,分离中高温大曲制作不同阶段微生物菌种,通过分子生物学技术并结合形态生理特征研究菌株在种水平上的分类学地位,建立中高温大曲微生物菌种资源库。
2.1.1 微生物群落结构分析
大曲培制是多菌种自然发酵过程,微生物种类复杂,数量众多,解析其微生物种群的组成及变化规律,对于酿造微生物的分离及功能解析具有积极的指导作用。高通量测序技术可以深入研究环境样品中微生物的群落组成和功能菌株,本研究选取两个地区中高温大曲制作不同阶段样品,应用改良的CTAB法提取样品总 DNA 后,基于 PacBio 测序平台,利用单分子实时测序(SMRT Cell)的方法对 marker 基因进行测序,之后通过对 CCS(Circular Consensus Sequencing),分析样品的物种构成。
2.1.2 酿造微生物菌株分离
白酒酿造研究中,微生物纯菌种的获得非常重要。虽然分子生物学技术可发现微生物物种、遗传、代谢等方面丰富的多样性, 但是单纯运用分子生物学技术对复杂体系中特异微生物群体进行生理学和代谢分析还存在很大的难度。尤其是研究微生物功能、微生物互作关系、发酵机理等更需在纯菌种基础上进行。我们基于高通量测序分析的样品物种构成并结合大曲在白酒生产中的作用构建酿造微生物菌株的分离筛选模型,主要构建了产生蛋白酶、淀粉酶、纤维素酶、脂肪酶、单宁酶、乙醇等菌株的分离筛选模型。针对一些酿造中丰度较高、常规方法不易分离或以往研究较少的微生物菌种如高温放线菌、链霉菌、嗜热真菌、乳酸菌等,通过培养基成分设计、培养温度控制及培养时间变化等方法,建立微生物菌株分离筛选模型,主要示例如下:
2.1.2.1 芽孢杆菌的分离
虽然高通量测序反映芽孢杆菌相对丰度并不是特别高,但实践表明芽孢杆菌在白酒酿造中是重要的微生物菌种。芽孢杆菌因为要产生芽孢,耐热性能较好,因此在分离时先将样品于80℃水浴10 min,再进行涂布稀释分离。
2.1.2.2 乳酸菌的分离
微生物群落结构分析的结果表明乳酸菌是大曲制作起始阶段的主要类群,因为怕乳酸乙酯过高,乳酸菌在白酒酿造中通常被认为是有害菌,需要抑制其生长。而乳酸菌在其它的发酵食品如酸奶、奶酪、泡菜、豆瓣等及人体益生菌中均是主要的功能菌,乳酸菌代谢的乳酸是发酵食品中的重要风味成分,白酒中的适量的乳酸对白酒的风味也有积极的贡献,能够掩盖酒精的味道,从而降低白酒的刺激感,增加酒体的绵柔度,并且能有效地缓解酒中的酯类水解,促进酒体的稳定。乳酸与发酵环境中其它物质反应生成的乳酸乙酯香味弱,味微甜,可增加酒体的醇甜感和醇厚度,延长酒体的后味,较高含量的乳酸乙酯是中国白酒区别于国外蒸馏酒的显著特征。乳酸菌产生的乳酸还可维持酸性的酿造环境,有效地抑制部分杂菌的代谢活动,改善酿造生产的微生态环境。
无论是抑制或是利用,纯菌种的获得都是必要的。乳酸菌耐酸、耐缺氧环境,因此在分离乳酸菌时在平皿上涂布少量乳酸以降低培养基的pH值,并且培养时将培养罐抽真空0.09 MPa。
2.1.2.3 酵母菌的分离
酵母菌是白酒自然发酵中的重要微生物,其代谢产物是呈味和呈香物质的主要组分。酵母菌可代谢乙醇、乙酸、乙酸乙酯等,乙酸乙酯及乙醇参与形成的乳酸乙酯、己酸乙酯等是白酒的骨架风味成分。高通量测序的结果表明酵母菌是大曲发酵初始阶段的主要菌群,酵母菌的繁殖可形成低氧、微酸环境,加上乙醇的作用,可抑制杂菌,从而净化酿造的微生态环境。酵母菌分离相对容易,通常酵母菌的分离采用麸皮汁琼脂和麦芽汁琼脂,为了增加分离到的酵母菌种类,我们还采用了PDA、IPS2、YPD、豆芽汁等多种培养基。
2.1.2.4 红曲霉的分离
红曲霉发酵产物红曲是食疗两用的传统中药材,在食品及中药上的应用已逾千年。最早被用于酿造黄酒,后来在制造腐乳、食醋、食用色素及中药上均有广泛应用。红曲霉嗜酸,特别喜乳酸,耐高温,耐乙醇,耐缺氧,能产生蛋白酶、淀粉酶、果胶酶、酯化酶等多种酶,并能产生红曲色素、Monacolin类化合物、GABA、黄酮酚、麦角固醇等次生代谢产物,具有降胆固醇、降血压、抗菌、抗氧化等生理活性。基于红曲霉的特点,我们在分离时先采用含有乳酸、乙醇的培养基对样进行富集培养,富集培养后再进行红曲霉的分离。
2.1.2.5 嗜热真菌的分离
中高温大曲的制作大部分时间是在45℃以上的温度下进行,微生物多样性分析表明中后期大曲中的真菌主要以曲霉和嗜热真菌为主。由于嗜热真菌生长的最适温度在40℃以上,实验室常用分离真菌的温度条件下较难生长或不生长,不易被分离到,白酒酿造中嗜热真菌的分离及其功能研究较少。我们通过将分离筛选温度提高到40度以及和增加培养基中氮源比例,建立了大曲中嗜热真菌的分离筛选模型。
2.1.2.6 放线菌的分离
放线菌是食品酿造的重要功能微生物,可产生淀粉酶、蛋白酶、纤维素酶、挥发性香味成分等,影响着食品的风味、风格等。高通量测序分析表明大曲在后期阶段放线菌尤其是高温放线菌数量较多,由于放线菌的生长速度相对细菌较慢,常规分离方法不易分离到放线菌,我们采用在培养基中添加抗细菌抗生素和抗真菌抗生素避免细菌和真菌的干扰,并且通过提高培养温度的方法分离高温放线菌。
此外,还通过培养基和培养温度等的改变,对大曲中的丝状真菌进行了初步分离。
2.1.3 酿造微生物菌株鉴定
对分离获得的酿造微生物菌株,通过形态特征和r DNA序列分析对其进行了分类学鉴定:细菌和酵母菌采用划线法、丝状真菌采用点接法培养后观察菌落形态;细菌采用革兰氏染色、真菌采用直接制片观察显微形态;采用CTAB法提取菌株总DNA,细菌以27F/1492R为引物、真菌以ITS1/ITS4为引物进行PCR扩增,扩增后的片段测序后采用NCBI的BLAST搜索程序,将实验中得到的序列信息与基因库中的基因序列进行比较获得同源性分析结果,综合形态特征和同源性分析结果,获得菌株的分类学信息。
2.1.4 菌株性能分析
基于微生物菌株的分离基质,通过模拟大曲培养制条件对微生物进行培养,综合多种方法对培养物进行分析检测:采用生物化学方法分析培养物的酶活性;采用气相色谱(GC)、气相色谱-质谱联用(GC-MS)、液相色谱(HPLC)等分析菌株培养物的挥发性成分和非挥发性成分,重点分析微生物代谢产物功能性成分和风味物质特征;借鉴现代天然产物化学研究的思路,对酿造微生物次生代谢产物进行系统分离和结构鉴定等,系统解析微生物菌种在大曲制造过程中的作用,目前主要研究了菌株的产酶性能和产乙醇性能。
2.1.4.1 菌株产酶性能
白酒酿造原料中存在淀粉、蛋白质、纤维素等大分子物质,这些物质需在淀粉酶、糖化酶、蛋白酶、纤维素酶等的作用下分解成还原糖、氨基酸等小分子物质才能进而产生呈香、呈味、呈色物质,因而产生酶的微生物在白酒酿造中是重要的功能微生物。将分离到的细菌接种于牛肉膏蛋白胨琼脂斜面培养基、酵母菌接种于麸皮汁琼脂斜面培养基、丝状真菌接种于PDA斜面培养基,培养活化后细菌转接于牛肉膏蛋白胨液体培养基、酵母菌接种于麸皮汁液体培养基振荡培养为液体种再转接于麸皮固体培养基中发酵4-6 d,丝状真菌活化后的斜面直接转接于麸皮固体培养基中发酵4 d。固体发酵后的培养物加水至稀释20倍,40℃水浴1h,间断搅拌,过滤,滤液即为待测酶液。酶活性测定分别采用下述方法:淀粉酶活性采用淀粉酶检测试剂盒(碘-淀粉比色法,Beijing Leagene Biotechnology Co,Ltd.)分析;糖化酶按QBT4257-2011(酿酒大曲通用分析方法)进行;酸性蛋白酶和中性蛋白酶按SB/T 10317-1999方法测定。
2.1.4.2 菌株产乙醇性能
将酵母菌株接种于麸皮汁琼脂斜面培养基,30℃培养1-2 d后转接于含4%葡萄糖的10%豆芽汁液体培养基中,30℃、150 r/min振荡培养1 d后再静置培养3 d,取培养物过滤后GC检测乙醇;细菌菌株接种于牛肉膏蛋白胨琼脂斜面培养基,30℃培养1 d后转接于含2%葡萄糖的牛肉膏蛋白胨液体培养基,30℃、150 r/min振荡培养1 d后再静置培养3 d,培养物过滤后GC检测乙醇。
2.2不同微生物菌种活菌数的定量分析
针对不同微生物特有基因序列,设计专一引物,采用qPCR技术对大曲制作关键时间节点的不同菌种微生物进行定量分析,确定不同微生物菌种在大曲发酵过程中的生长、繁殖及消亡过程,分析微生物在大曲微生态形成过程中的演替规律,确定不同微生物菌种在大曲制作过程中的角色--功能菌(参与大曲发酵)和非功能菌(仅存在但不参与大曲发酵),进而确定中高温大曲的主要功能微生物。
2.3 代表性菌种的代谢产物研究
针对大曲中的一些代表性菌种,通过固态发酵,有机溶剂浸提,色谱柱分离纯化,利用核磁共振、质谱、高效液相色谱质谱联用等现代波谱技术对菌种次级代谢产物进行结构鉴定,研究阐明其与大曲酿造相关的生物活性。
❸
研究成果
3.1 中高温大曲微生物菌种资源库的建立
3.1.1 微生物多样性分析
3.1.1.1 细菌
A. 企业1
入房曲中细菌相对丰度最高的是泛菌属的成团泛生菌(Pantoea agglomerans),相对丰度为40.8%,其次是属于乳酸菌类的融合魏斯氏菌(Weissella confusa),相对丰度为32.7%。
发酵初期相对丰度最高的是融合魏斯氏菌(Weissella_confusa),相对丰度为38.8%,其次为乳酸菌类的食品乳杆菌(Companilactobacillus paralimentarius),相对丰度为27.8%。
发酵中前期相对丰度最高的成团泛生菌(Pantoea agglomerans),相对丰度为29.4%,其次为腐生葡萄球菌(Staphylococcus saprophyticus)和阴沟肠杆菌(Enterobacter cloacae),相对丰度分别为14%和13.2%。
发酵中后期相对丰度最高的是克罗彭斯特菌属的Kroppenstedtia eburnea,相对丰度为53.7%,其次是腐生葡萄球菌(Staphylococcus saprophyticus),相对丰度为10.9%。
贮存1个月大曲中相对丰度最高的是乳酸菌类的柠檬明串珠菌(Leuconostoc citreum),相对丰度为40.9%,其次为克罗彭斯特菌属的血液克罗彭斯特菌(Kroppenstedtia sanguinis),相对丰度为39.9%。
曲粉中相对丰度最高的是血液克罗彭斯特菌(Kroppenstedtia sanguinis),相对丰度为54.1%,其次是高温放线菌属的普通嗜热放线菌(Thermoactinomyces vulgaris),相对丰度为11.4%。
B. 企业2
入房曲中相对丰度最高的乳酸菌为的乳明串珠菌(Leuconostoc lactis),相对丰度为46.0%;其次是成团泛生菌(Pantoea agglomerans),其相对丰度为28.2%;第三是葡糖杆菌属的日本葡糖杆菌(Gluconobacter japonicus),相对丰度为8.6%。
发酵1天的曲中相对丰度最高的是葡萄球菌属的鸡葡萄球菌(Staphylococcus gallinarum),相对丰度为57.5%。其次是乳酸菌类的发酵乳酸杆菌(Limosilactobacillus fermentum)和植物乳植杆菌(Lactiplantibacillus plantarum),相对丰度分别为22.6%和7.8%。
发酵3天的曲中相对丰度最高的是发酵乳酸杆菌(Limosilactobacillus fermentum),相对丰度为47.3%;其次是鸡葡萄球菌(Staphylococcus gallinarum)和乳酸菌类的戊糖片球菌(Pediococcus pentosaceus),其相对丰度分别为28.1%和13.6%。
发酵5天的曲中相对丰度最高的是乳酸菌类的发酵乳酸杆菌(Limosilactobacillus fermentum),相对丰度为56.8%;其次是鸡葡萄球菌(Staphylococcus gallinarum)和戊糖片球菌(Pediococcus pentosaceus),相对丰度分别为26.6%和8.2%。
发酵8天的曲中相对丰度最高的是鸡葡萄球菌(Staphylococcus gallinarum),相对丰度为48.6%;其次是发酵乳酸杆菌(Limosilactobacillus fermentum)和霍氏糖多孢菌(Saccharopolyspora hordei),相对丰度分别为14.3%和8.5%。
发酵11天中相对丰度最高的是大曲高温放线菌(Thermoactinomyces daqus),相对丰度为50.4%;其次是鸡葡萄球菌(Staphylococcus gallinarum)和发酵乳酸杆菌(Limosilactobacillus fermentum),相对丰度分别为17.7%和12.5%。
发酵15天曲中相对丰度最高的是直杆糖多孢菌(Saccharopolyspora rectivirgula),相对丰度为39.2%;其次是普通高温放线菌(Thermoactinomyces vulgaris)和鸡葡萄球菌(Staphylococcus gallinarum),相对丰度分别为10.0%和 9.2%。
发酵20天曲中相对丰度最高的血液克罗彭斯特菌属(Thermoactinomyces sanguinis),相对丰度为56.6%;其次是直杆糖多孢菌(Saccharopolyspora rectivirgula),相对丰度为32.7%。
发酵25天曲中相对丰度最高的是直杆糖多孢菌(Saccharopolyspora rectivirgula),相对丰度为28.1%;其次是发酵乳酸杆菌(Limosilactobacillus fermentum)和普通高温放线菌(Thermoactinomyces vulgaris)和,相对丰度分别为16.9%和10.0%。
发酵30天的曲中相对丰度最高的是直杆糖多孢菌(Saccharopolyspora rectivirgula),相对丰度为44.2%;其次是鸡葡萄球菌(Staphylococcus gallinarum),其相对丰度为19.3%。
两家企业的大曲发酵前期均以乳酸菌为主,发酵过程中葡萄球菌数量较多,后期以耐高温的高温放线菌为主。芽孢杆菌的数量较少,相对丰度均在5%以下。
3.1.1.2 真菌
A.企业1
入房曲中相对丰度最高的是损毁链格孢(Alternaria destruens),相对丰度为71.9%。
发酵初期相对丰度最高的是节孢酵母属的Blastobotrys raffinosifermentans,相对丰度为34.8%,其次是库德里阿兹氏毕赤酵母(Pichia kudriavzevii),相对丰度为19.8%。
发酵中前期相对丰度最高的是嗜热子囊菌(Thermoascus aurantiacus),相对丰度为43.8%,其次是库德里阿兹氏毕赤酵母(Pichia kudriavzevii),相对丰度为22.1%。
发酵中后期相对丰度最高的是嗜热子囊菌(Thermoascus aurantiacus),相对丰度为83.0%,其次是疏棉状嗜热丝孢菌(Thermomyces lanuginosus),相对丰度为8.3%。
贮存1个月曲中相对丰度最高的嗜热子囊菌(Thermoascus aurantiacus),相对丰度为55.2%,其次是米曲霉(Aspergillus oryzae),相对丰度为21.5%。
曲粉中相对丰度最高的是嗜热子囊菌(Thermoascus aurantiacus),相对丰度为51.7%,其次是疏棉状嗜热丝孢菌(Thermomyces lanuginosus),相对丰度为17.6%。
企业2的真菌结果还在检测中。
发酵前期真菌以酵母为主,中后期以耐热的嗜热真菌为主,贮存后曲霉数量增加。
3.1.2 酿造微生物菌株分离、鉴定及性能分析
白酒酿造研究中,微生物纯菌种的获得非常重要。虽然分子生物学技术可发现微生物物种、遗传、代谢等方面丰富的多样性, 但是单纯运用分子生物学技术对复杂体系中特异微生物群体进行生理学和代谢分析还存在很大的难度。尤其是研究微生物功能、微生物互作关系、发酵机理等更需在纯菌种基础上进行。我们以高通量测序获得的群落结构为基础,以生物酶、风味成分、生理活性成分及特定菌株为筛选目标,设计培养基和培养条件,分离收集大曲微生物,共获得100个种的微生物菌种。以下示例部分菌株的分离结果。
(1)芽孢杆菌
芽孢杆菌是大曲中的主要微生物,尤其是大曲制作后期,随着温度的升高,其它不耐热的细菌逐渐衰亡,芽孢杆菌成为优势微生物。目前我们从两个企业的中高温大曲中共分离到9种芽孢杆菌(表-1),除特基拉芽孢杆菌和阿耶波多芽孢杆菌外,其它菌种在两种大曲中均分离到,定性分析表明这些芽孢杆菌均能产生蛋白酶和淀粉酶。


(2)乳酸菌
微生物群落结构分析的结果表明乳酸菌是大曲制作起始阶段的主要类群,因为怕乳酸乙酯过高,乳酸菌在白酒酿造中通常被认为是有害菌,需要抑制其生长。而乳酸菌在其它的发酵食品如酸奶、奶酪、泡菜、豆瓣等及人体益生菌中均是主要的功能菌,乳酸菌代谢的乳酸是发酵食品中的重要风味成分,白酒中的适量的乳酸对白酒的风味也有积极的贡献,能够掩盖酒精的味道,从而降低白酒的刺激感,增加酒体的绵柔度,并且能有效地缓解酒中的酯类水解,促进酒体的稳定。乳酸与发酵环境中其它物质反应生成的乳酸乙酯香味弱,味微甜,可增加酒体的醇甜感和醇厚度,延长酒体的后味,较高含量的乳酸乙酯是中国白酒区别于国外蒸馏酒的显著特征。乳酸菌产生的乳酸还可维持酸性的酿造环境,有效地抑制部分杂菌的代谢活动,改善酿造生产的微生态环境。
无论是抑制或是利用,纯菌种的获得都是必要的,通过设计培养基组分、改变培养条件等方法,目前从两个大曲样品中分离到7种乳酸菌(表-2),除了产乳酸外,这些菌株其它的作用还有待深入研究。


(3)放线菌
放线菌是食品酿造的重要功能微生物,可产生淀粉酶、蛋白酶、纤维素酶、挥发性香味成分等,影响着食品的风味、风格等。放线菌在大曲制作阶段普遍存在,尤其中后期,由于温度的升高,一些耐热的放线菌大量繁殖。常规分离大曲微生物时,由于其它细菌的迅速生长,抑制了放线菌的繁殖,我们通过培养基成份的调整及应用不同培养温度,在大曲制作的不同阶段均分离到了放线菌,目前共分离到5个种(表-3),其中3种均属于高温放线菌,最适生长温度45℃,能在50℃生长。


(4)酵母菌
酵母菌是白酒自然发酵中的重要微生物,其代谢产物是呈味和呈香物质的主要组分。酵母菌可代谢乙醇、乙酸、乙酸乙酯等,乙酸乙酯及乙醇参与形成的乳酸乙酯、己酸乙酯等是白酒的骨架风味成分。高通量测序的结果表明酵母菌是大曲发酵初始阶段的主要菌群,酵母菌的繁殖可形成低氧、微酸环境,加上乙醇的作用,可抑制杂菌,从而净化酿造的微生态环境。通过对不同发酵阶段大曲的分离筛选,目前共获得12种酵母菌(表-4,图-4)。


(5)红曲霉
红曲霉的发酵产物红曲是食疗两用的传统中药材,在食品及中药上的应用已逾千年。最早被用于酿造黄酒,后来在制造腐乳、食醋、食用色素及中药上均有广泛应用。红曲霉嗜酸,特别喜乳酸,耐高温,耐乙醇,耐缺氧,能产生蛋白酶、淀粉酶、果胶酶、酯化酶等多种酶,并能产生红曲色素、Monacolin类化合物、GABA、黄酮酚、麦角固醇等次生代谢产物,具有降胆固醇、降血压、抗菌、抗氧化等生理活性。
大曲起始阶段乳酸菌和酵母菌的生长提供了乳酸、乙醇,为红曲霉提供了适宜的生长条件,大曲中红曲霉产生的各种酶系可将大分子物质酶解,为白酒香味物质的产生提供前体物质,次生代谢产物还可增加白酒中具生理活性的微量成分。我们从两种大曲中分离到4种红曲霉(表-5),均能在2%乳酸或10%乙醇中生长,能产生酯化酶、淀粉酶、蛋白酶。
表-5 大曲中分离到的红曲霉

(6)其他丝状真菌
米曲霉、黑曲霉、根霉、毛霉等丝状真菌可产生蛋白酶、淀粉酶等生物酶,可将粮谷原料中的蛋白质、淀粉等酶解成小分子物质,可为产酒、产香提供前体物质。通过培养基和培养温度等的改变,对大曲中的丝状真菌进行了初步分离,除分离到上述常见丝状真菌外,还分离到多种目前研究较少的丝状真菌,示例如下表。
表-6 大曲中分离到的丝状真菌

除上述示例的53种菌种外,在大曲中分离到的其它47种菌种名称如表-7
表- 7 大曲中的其它微生物菌种


3.3 典型菌株代谢产物分析
3.3.1大曲中的谢瓦散囊菌研究
(1)散囊菌次级代谢产物分离纯化和结构鉴定
散囊菌是一类嗜高渗透压的微生物,孢子中度耐热,能适应高糖、高盐等形成的高渗环境,茯砖茶中“金花”的优势微生物是冠突散囊菌,冠突散囊菌是茯砖茶中香味的主要来源,气相色谱分析表明茯砖茶内的醛酮类化合物和吡嗪类杂环化合物的含量都随茯砖茶中散囊菌的变化而变化,说明散囊菌具有一定的生香或促进产香的功能。
大曲中散囊菌广泛存在,尤其大曲制作中后期,大曲断面呈现的黄色点状区中散囊菌数量较多。因此,我们利用微生物分离纯化技术获得了大曲中的散囊菌,并通过宏观微观形态观察与ITS分子测序技术将其鉴定为谢瓦散囊菌(Eurotium Chevalieri YT411)(图-15)。
图-15 谢瓦散囊菌菌丝体及形态特征(Eurotium Chevalieri YT411)
为阐明酿酒大曲中散囊菌的次级代谢产物,我们采用规模化培养方式对该菌固态发酵,进一步采用有机溶剂浸提、色谱层析分离和核磁共振(NMR)、质谱(MS)等波谱手段对散囊菌的次级代谢产物进行了深入研究,发现谢瓦散囊菌YT411能够产生多种类型的活性次级代谢产物,包括2-hydroxydiplopterol(1)、大黄素(2)、大黄素甲醚(3)、大黄酸(4)、11,14-dihydroxylneoechinulin E(5)、、neoechinulin E(6)、neoechinulin A(7)、echinulin(8)、eurocristatine(9)和cristatumin E(10)、hexylitaconic acid(11)和kojic acid(12)(图-16)。

图-16 散囊菌次级代谢产物
(2)谢瓦散囊菌代谢产物的化学生态学研究
微生物次级代谢产物是微生物之间相互作用的桥梁,产生具有抗菌活性的小分子次级代谢产物是微生物生存和竞争的重要方式。因此,我们对谢瓦散囊菌中分离得到的次级代谢产物进行了抗菌活性的研究。研究结果表明,谢瓦散囊菌产生的大黄素(2)、大黄素甲醚(3)和大黄酸(4)在100μg/mL的浓度下能够显著抑制金黄色葡萄球菌(S. aureus)和粪肠球菌(E. faecalis)的生长。生物膜是微生物群落附着在基质或表面并被自身合成的胞外基质包裹形成的复合物。细菌生物膜为细菌提供保护层,阻止抗生素进入,使细菌表现出抗抗生素能力。因此,进一步测试了谢瓦散囊菌次级代谢产物抑制细菌生物膜形成的活性,结果显示大黄素(2)、大黄素甲醚(3)和大黄酸(4)均能抑制金黄色葡萄球菌生物膜的形成。而二酮哌嗪类化合物化合物neoechinulin A(7)、echinulin(8)和eurocristatine(9)能够抑制大肠杆菌生物膜的形成。
同时,我们发现化合物11,14-dihydroxylneoechinulin E属于铁离子载体分子,其具有十分强的铁离子结合能力,能从铁离子浓度极低的环境下收集铁离子,将其转运到菌体内,为散囊菌的生长提供必须的铁元素。同时,其它的二酮哌嗪类分子也是铁载体分子的前体物质。因此散囊菌中高含量的二酮哌嗪类次级代谢产物在其生存、繁殖和竞争中发挥重要作用。
(3)大曲中谢瓦散囊菌代谢产物分析
建立谢瓦散囊菌特征次级代谢产物的指纹谱图,对研究散囊菌在大曲中的演替规律及机制具有重要意义。因此,我们摸索建立了谢瓦散囊菌次级代谢产物的高效液相指纹谱图,并利用高效液相色谱和高分辨质谱联用技术(HPLC-MS)对散囊菌固态发酵物中特征次级代谢产物进行了分析,通过紫外特征谱图和准确分子式确定了谢瓦散囊菌特有二酮哌嗪类次级代谢产物主要包括:Neoechinulin E(6)、neoechinulin A(7)、echinulin(8)、eurocristatine(9)和cristatumin E(10)(图-17)。其中新海胆灵A(Neoechinulin A,tR=1.41)和海胆灵(Echinulin,tR=8.36)在散囊菌次级代谢产物中含量较高,适合作为大曲中谢瓦散囊菌定性分析的特征指纹分子。

图-17散囊菌次级代谢产物UPLC指纹图谱

图-18 散囊菌次级代谢产物离子流图
表-8 谢瓦散囊菌特有的二酮哌嗪次级代谢产物

取不同发酵培养时间的大曲,以乙酸乙酯对大曲中散囊菌特征代谢产物,进行了提取,进一步通过HPLC-HRESIMS技术对大曲提取物中散囊菌特征代谢产物Neoechinulin A(tR = 1.41)和Echinulin(tR = 8.36)进行了定性分析,结果表明培养20天的大曲中可以明显检测到散囊菌特征代谢产物(图-19,20)。

图-19大曲中Neoechinulin A的离子流及分子量

图-20 大曲中Echinulin A的离子流及分子量
通过对分离得到的次级代谢产物的结构特点和活性分析,首次发现大曲中的散囊菌能够代谢产生一种具有广泛抗菌活性的蒽醌类小分子化合物大黄酸,其在大曲中散囊菌的生在繁殖竞争中扮演了十分重要的作用。同时,我们首次分析发现,该散囊菌还代谢产生了结构类型丰富的二酮哌嗪类化合物,该类化合物为铁载体小分子化合物,其具有十分强的铁离子络合能力,可以帮助散囊菌在大曲中获得微生物生长必须的铁离子,通过竞争,可以剥夺其它微生物生长必须的铁离子,进而获得生长繁殖的竞争优势。该研究为大曲中功能微生物之间的化学生态学相互作用研究提供了新的思路。
(4)散囊菌与大曲中代表性微生物相互作用研究
在大曲发酵后期,散囊菌逐渐发展演替成为了优势菌群,研究散囊菌与其它菌的相互作用可一定程度揭示其演替机制。因此,我们将散囊菌与大曲中代表性菌株放线菌、地衣芽孢杆菌杆菌分别进行了共培养实验。实验结果表明,在放线菌和散囊菌共培养中,散囊菌生长菌丝体显著增加,散囊菌能够产生更多的色素代谢产物。对共培养中散囊菌特有次级代谢产物的含量分析表明,与放线菌共培养促进了散囊菌中代谢产物Neoechinulin A(tR=6.36)和Echinulin(tR=24.02)合成,其产量分别提高了11.7%和9.7%(图-21)。当散囊菌与地衣芽孢杆菌共培养时,散囊菌菌丝体显著减少,地衣芽孢杆菌抑制散囊菌的生长,同时散囊菌的特有代谢产物Neoechinulin A降低了70.6%、Echinulin降低了51.2%

图-21 散囊菌、放线菌和地衣芽孢杆菌共培养指纹图谱
3.3.2 大曲中菌核青霉代谢产物研究
前期在对大曲中微生物的分离中得到了一株菌核青霉,通过色谱分离和波谱鉴定对该菌固态发酵物中的次级代谢产物进行了研究,在该菌中鉴定了一系列azaphilone类真菌色素和一些酚酸类化合物(图-22)。抗菌活性表明azaphilone类真菌色素和酚酸类化合物2,4-dihydroxy-6-((3E,5E)-nona-3,5-dien-1-yl)-benzoic acid (4), carnemycin B (5), stromecycin (6)对革兰氏阳性菌枯草芽孢杆菌和金黄色葡萄球菌具有一定的生长抑制活性。

图-22 菌核青霉的次级代谢产物
3.3.3 根霉次级代谢产物研究
根霉是大曲发酵中常见的功能微生物,研究根霉的次级代谢产物,分析其结构与功能将有助于了解根霉在大曲演替机理。因此,我们对根霉进行了固态培养,并利用色谱和波谱技术对根霉的次级代谢产物进行了研究,从根霉发酵物中分离鉴定了8个主要成分,主要包括麦角甾醇(1)、过氧麦角甾醇(2)、3,5,6-三羟基麦角甾醇(3)、对羟基苯甲酸(4)、对羟基苯甲酸甲酯(5)、对羟基苯乙酸(6)、对羟基苯乙酸甲酯(7)、3-(4-羟基苯基)乳酸(8)和L-苯基乳酸(9),其结构如图所示。

图-23 根霉次级代谢产物
3.3.4大曲来源的根毛霉、黑曲霉、米曲霉、圆弧青霉、热子囊菌真菌次级代谢产物研究
以麸皮为培养基,对大曲来源的根毛霉、黑曲霉、米曲霉、圆弧青霉和热子囊菌进行了固态发酵,发酵时间为15天。发酵完成后,采用薄层层析色谱技术(thin layer chromatography)对其固态发酵物中的次级代谢产物分析了,分析结果表明这几种真菌的次级代谢产物种类较单一,特征成分基本一致,主成分包括麦角甾醇、过氧麦角甾醇和一些有机酸类分子。
3.4 大曲中代表性微生物之间互作研究
以麸皮为原料,将大曲来源的代表性微生物地衣芽孢杆菌、白色链霉菌、散囊菌、根毛霉、黑曲霉、米曲霉和热子囊菌进行组合共培养实验,通过薄层层析色谱技术分析共培养菌株的生长情况,结果表明白色链霉菌与米曲霉、散囊菌、黑曲霉、热子囊菌具有互生关系,其对米曲霉和散囊菌的促生长效果尤为显著,但地衣芽孢杆菌对米曲霉、根霉、热子囊菌、根毛霉和黑曲霉的生长菌表现出抑制作用。
❹
成果表达
1、菌株实物100种;
2、申报专利三项,其中授权专利1项
(1)杨涛,李国友,陈晓珍,姚灿,一种产液化型淀粉酶的根毛霉菌及应用,授权(ZL201910726904.5)。
(2)李国友,张国林,杨涛,钱雪情,刘玲艳,秦张一,一种毛壳菌菌株及其发酵生产的具有神经保护活性的化合物,申请号:CN2022102144238。
(3)李国友,杨涛,张霞,张国林,一种具有抗炎活性的水溶性红色食用真菌色素及其制备方法和用途, 申请号:CN202110432757。
3、论文发表情况;
(1)Xia Zhang, Yeye Hu, Tao Yang, Xueqing Qian, Weicheng Hu, Guoyou Li. Penazaphilones J–L, Three new hydrophilic azaphilone pigments from Penicillium sclerotiorum cib-411 and their anti-inflammatory activity. Molecules, 2023, 28, 3146.
(2)Lingyan Liu, Xueqing Qian, Tao Yang, Dongmei Fang, Zhangyi Qin, Bo Ren, and Guoyou Li*, Cyclopiazonic Acid and Okaramine Analogues, Including Chlorinated Compounds, from Chrysosporium undulatum YT-1, Journal of Natural Products, 2022, 85(11): 2547-2556.
(3)张春英,秦张一,钱雪情,杨涛,李国友. 一株酿酒大曲菌散囊菌次级代谢产物及生物活性研究(待发表)。
(4)张春英,杨涛,李国友. 酿酒大曲中几种优势微生物演替规律研究(待发表)。
❺
行业效益与人才培养
为企业技术人员进行了大曲功能微生物分离鉴定相关培训,共3人。
为行业培养从事酿酒微生物活性物质研究的研究生2人。
❻
下一步研究计划
1、系统考察大曲中微生物的生长变化规律,确定大曲酿造的功能微生物菌种。
2、比较不同大曲中优势功能菌株的差异和演替规律。
